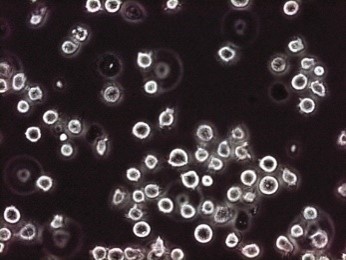

スーパーオキシド検出プローブ
スーパーオキシドは活性酸素の一種であり、その反応性の高さにより生体分子を損傷させる原因となります。活性酸素が過剰な状態である、いわゆる酸化ストレスが高い状態が続くと、生活習慣病や神経変性疾患など様々な疾患が引き起こされます。これまでスーパーオキシドの検出プローブとしてヒドロエチジンがよく用いられていました。しかしながら、ヒドロエチジンはスーパーオキシドへの特異性に問題があり、より特異性の高い蛍光プローブの開発が求められていました。
当社ではスーパーオキシドの蛍光プローブとしてBES-So-AM/BES-Soを取り扱っております。本製品は従来の蛍光プローブであるヒドロエチジンと比較して、スーパーオキシドに対する特異性が高く、バックグラウンドを低減することができます。蛍光顕微鏡による生細胞のイメージングやフローサイトメトリーによる細胞分析に使用することが可能です。
スーパーオキシドとは?
スーパーオキシド (Superoxide) は活性酸素の一種であり、酸素分子が一電子還元を受けることで生成されます (O2-・)。スーパーオキシドアニオンやスーパーオキシドラジカル、スーパーオキシドアニオンラジカルとも呼ばれます。生体で発生したスーパーオキシドは、その反応性の高さにより生体分子を損傷させる原因となります。活性酸素が過剰な状態である、いわゆる酸化ストレスが高い状態が続くと、生活習慣病や神経変性疾患など様々な疾患が引き起こされます。正常な細胞では発生したスーパーオキシドを速やかに除去する機能 (抗酸化能) が備わっており、スーパーオキシドの除去に関与する分子として、一酸化窒素 (NO・) やスーパーオキシドジスムターゼ (SOD) が知られています。
スーパーオキシドは極性溶媒中では速やかに過酸化水素 (H2O2) に変換されるため、直接測定することが難しい分子です。スーパーオキシドの測定には、過酸化水素 (H2O2) よりも早い反応速度で進行する化学反応を用いる必要があり、チトクロームCやニトロブルーテトラゾリウム (NBT) の還元を利用した方法が知られています1)。また蛍光プローブはスーパーオキシドを簡便に測定する方法として有用であり、従来はヒドロエチジン (HE: Hydroethidine) がよく用いられていました。しかしながら、ヒドロエチジンはスーパーオキシドへの特異性に問題があり2)、より特異性の高い蛍光プローブの開発が求められていました。
スーパーオキシド特異的蛍光プローブ BES-So-AM/BES-So
BES-So-AMおよびBES-Soは、生細胞内のスーパーオキシドを検出するための蛍光プローブです2-3)。本製品は酸化還元反応に依存しないメカニズムによって蛍光を発します。従来の蛍光プローブであるヒドロエチジンと比較して、スーパーオキシドに対する特異性が高く、バックグラウンドを低減することができます。蛍光顕微鏡による生細胞のイメージングやフローサイトメトリーによる細胞分析に使用することができます。
特長
- 生細胞のスーパーオキシドを検出
- 従来の蛍光プローブ (ヒドロエチジン) よりもスーパーオキシドに対する特異性が高い
- 水に溶解して使用可能
- Ex/Em=505 nm/544 nm
原理

データ
BES-So-AMによるJurkat T細胞のスーパーオキシド検出
Jurkat T細胞を33 μM BES-So-AMを含む培地で37℃、1時間培養して細胞内に試薬を取り込ませた。その後、スーパーオキシドを産生させるため、5 mM 酪酸を添加し、さらに1時間培養した。対照群ではスーパーオキシドのスカベンジャーであるTironをBES-So-AMとともに培地に添加した。
| O2ー・産生なし/スカベンジャーなし | O2ー・産生あり/スカベンジャーなし | O2ー・産生あり/スカベンジャーあり | |
| 蛍光像 | ![]() |
![]() |
![]() |
| 位相差像 | ![]() |
![]() |
![]() |
参考文献
- 須磨春樹編: 「活性酸素実験プロトコール」 (秀潤社) (1994).
- Maeda, H. et al.: J. Am. Chem. Soc., 127, 68(2005).
A design of fluorescent probes for superoxide based on a nonredox mechanism - Maeda, H. et al.: Chem. Eur. J., 13(7), 1946 (2007).
Design of a practical fluorescent probe for superoxide based on protection–deprotection chemistry of fluoresceins with benzenesulfonyl protecting groups.
製品一覧
- 項目をすべて開く
- 項目をすべて閉じる
BES-So-AM (細胞透過性)
BES-So (細胞非透過性)
- 掲載内容は本記事掲載時点の情報です。仕様変更などにより製品内容と実際のイメージが異なる場合があります。
- 掲載されている製品について
- 【試薬】
- 試験・研究の目的のみに使用されるものであり、「医薬品」、「食品」、「家庭用品」などとしては使用できません。
- 試験研究用以外にご使用された場合、いかなる保証も致しかねます。試験研究用以外の用途や原料にご使用希望の場合、弊社営業部門にお問合せください。
- 【医薬品原料】
- 製造専用医薬品及び医薬品添加物などを医薬品等の製造原料として製造業者向けに販売しています。製造専用医薬品(製品名に製造専用の表示があるもの)のご購入には、確認書が必要です。
- 表示している希望納入価格は「本体価格のみ」で消費税等は含まれておりません。
- 表示している希望納入価格は本記事掲載時点の価格です。